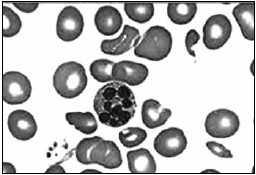
Enunciado 3519099-2

Foram encontradas 460 questões.
Uma das principais ameaças à saúde infantil é a desnutrição aguda grave. De acordo com a Organização Mundial da Saúde (OMS), cerca de 45% das mortes de crianças menores de cinco anos estão relacionadas com a desnutrição, acometendo, principalmente, países de baixa e média rendas. A seguir, encontra-se o resultado de uma eletroforese de proteínas e lâmina de esfregaço de sangue de uma criança 4 anos, que é de família de piaçabeiros, comunidade tradicional da Amazônia. Os dois resultados apontam, respectivamente, os seguintes diagnósticos e quadro de desnutrição da criança:
(Referência: https://www.msf.org.br/ Acesso em: 13 de julho de 2023)
Figura 1

Figura 2
(Laudo e imagem cedidos pelo Laboratório de Análises Clínicas do Centro Universitário FMABC)
Provas
Assinale a alternativa que apresenta o cálculo que estima a taxa de filtração glomerular, junto ao resultado de creatinina sérica, e que está sendo utilizado como principal exame de rastreio no mundo para doença renal, sem uso da raça, conforme diretriz de 2021 (Inker LA et al, 2021).
(Referência: Inker LA, Eneanya ND, Coresh J, Tighiouart H, Wang D, Sang Y, et al. New Creatinine- and cystatin C-based equations to estimate GFR without race. N Engl J Med. (2021). 10.1056/NEJMoa2102953 [PMC free article] [PubMed] [CrossRef] [Google Scholar]
Provas
A análise do resultado do exame de cadeia leve de imunoglobulina livre apresentado a seguir condiz com a seguinte patologia:
CADEIA LEVE DE IMUNOGLOBULINA LIVRE, soro
Método: Imunoturbidimetria
| RESULTADO |
VALOR DE REFERÊNCIA |
|
| Cadeias kappa livres.: |
0,09 mg/dL | 0,33 a 1,94 mg dL |
| (0,9 mL) | (3,3 a 19,4 mg/L) |
|
| Cadeias lambda livres: |
74,75 mg/dL |
0,57 a 2,63 mg/dL |
| (747,5 mg/L) |
(5,7 a 26,3 mg/L) |
|
| Relação kappa/lambda.: |
0,001 | 0,26 a 1,65 |
| Nota(1): Este laudo contempla os resultados nas concentrações mg/dL e mg/L. |
||
(Imagem cedida pelo Laboratório de Análises Clínicas do Centro Universitário FMABC)
Provas
Tem-se como constatação científica que há presença de receptor de vitamina D na maioria dos tecidos corporais, o que justifica a função de tal composto para a homeostase do organismo. A sarcopenia constitui-se em uma das quatro principais razões para a perda de massa muscular e atinge cerca de 5 a 13% dos idosos com idade entre 60 e 70 anos e 10 a 50% em idosos acima de 80 anos. Dados do Instituto Brasileiro de Geografia e Estatística (IBGE) mostram que, em 2019, a expectativa de vida no Brasil atingiu 76,6 anos. Em relação à vitamina D, para avaliar ou monitorar sua concentração sanguínea, deve-se solicitar a dosagem de:
Provas
No Brasil, de 2018 a 2021, a quantidade de pacientes em diálise aumentou de 133 464 para 148 363 segundo o censo de 2021 da Sociedade Brasileira de Nefrologia. Sabe-se que a avaliação da função renal é de extrema importância na prática clínica, tanto para o diagnóstico quanto para prognóstico e monitoração das doenças renais. Portanto, novos biomarcadores renais estão sendo utilizados para diagnóstico precoce, estratificação de risco, prognóstico de lesão renais agudas e crônicas. Estes biomarcadores de disfunção renal encontram-se disponíveis em laboratórios clínicos e correspondem a alternativa:
Provas
O laser mais utilizado na fotocoagulação retiniana é o
Provas
Em casos de endoftalmite exógena pós-traumática, os antibióticos mais utilizados atualmente para o tratamento por via intravítrea são
Provas
As drogas utilizadas no tratamento quimioterápico clássico do retinoblastoma são
Provas
A paralisia de III nervo causa
Provas
São fatores de risco para glaucoma primário de ângulo fechado (GPAF):
Provas
Caderno Container